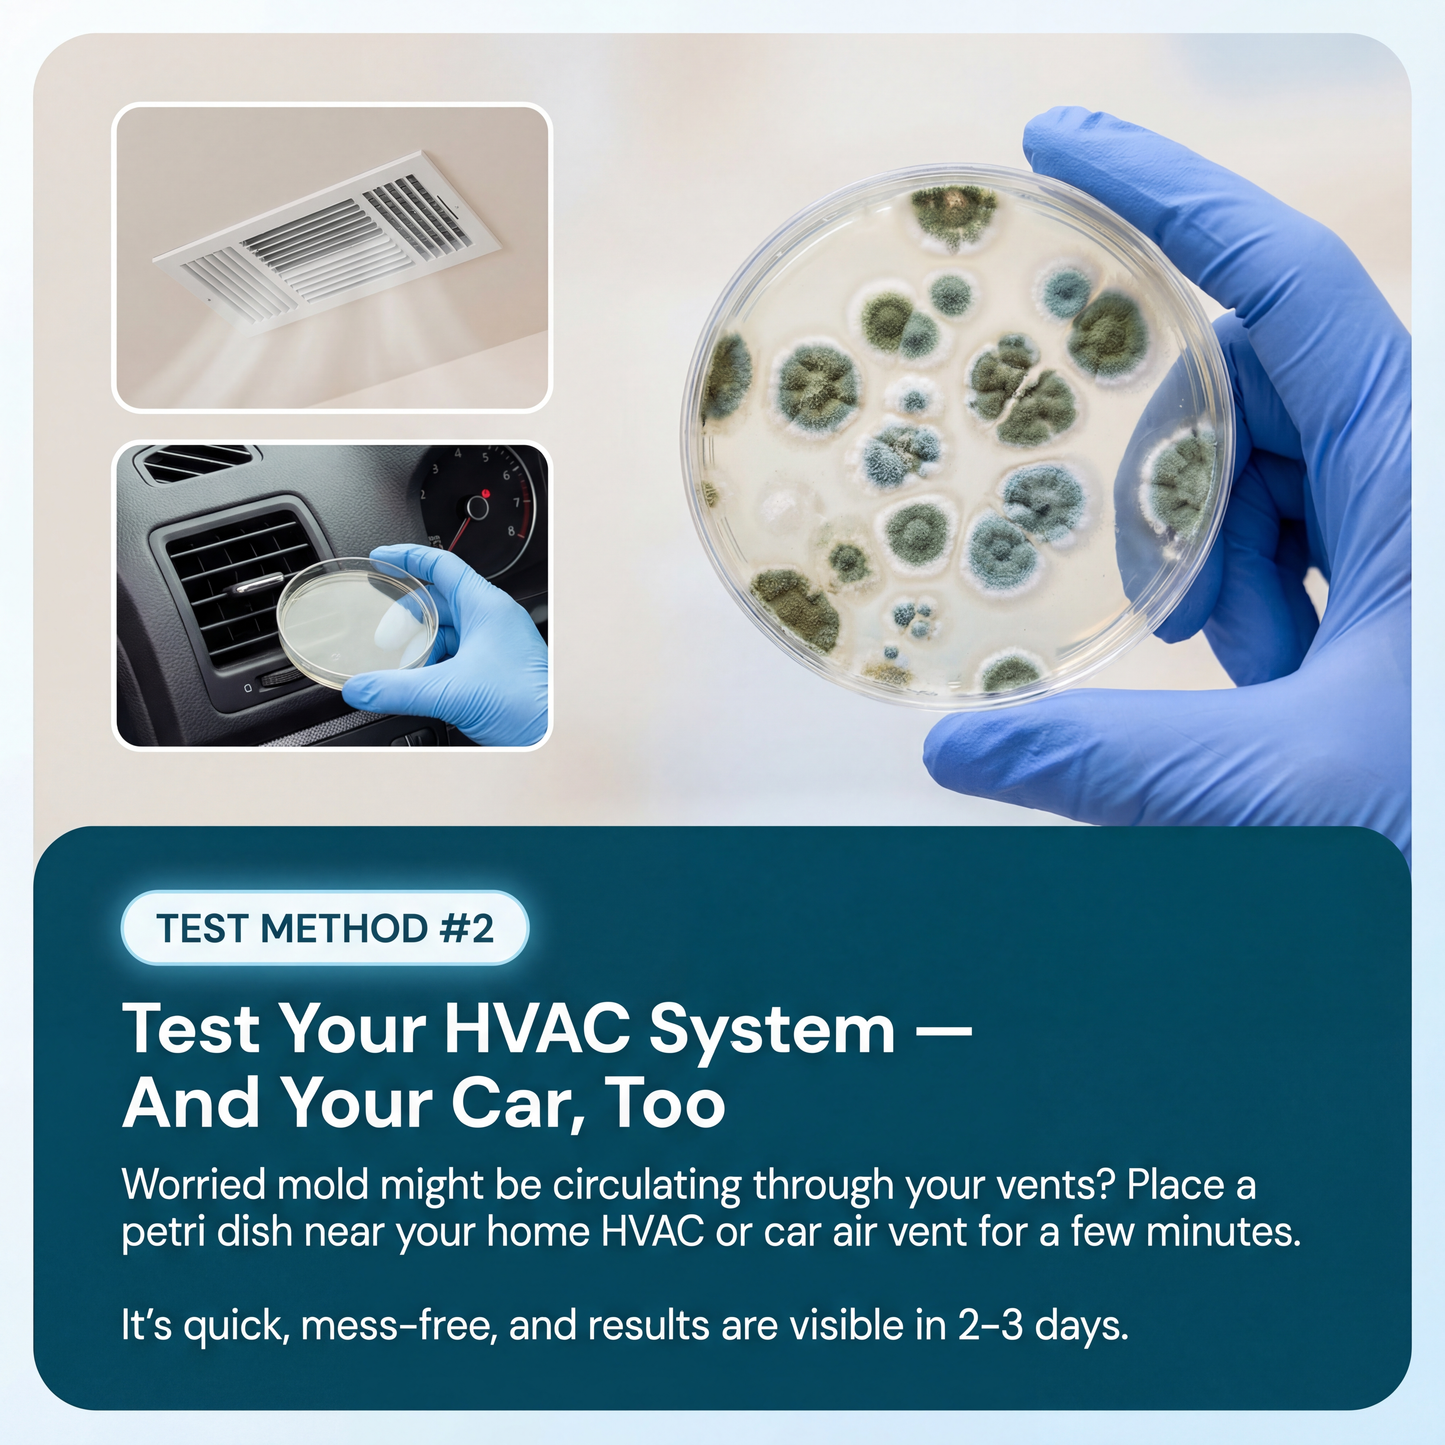
ClearSpace - Home Test Kit
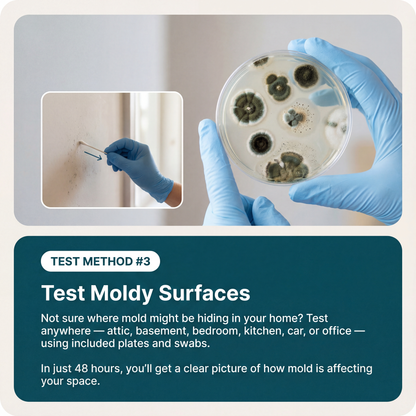
ClearSpace - Home Test Kit
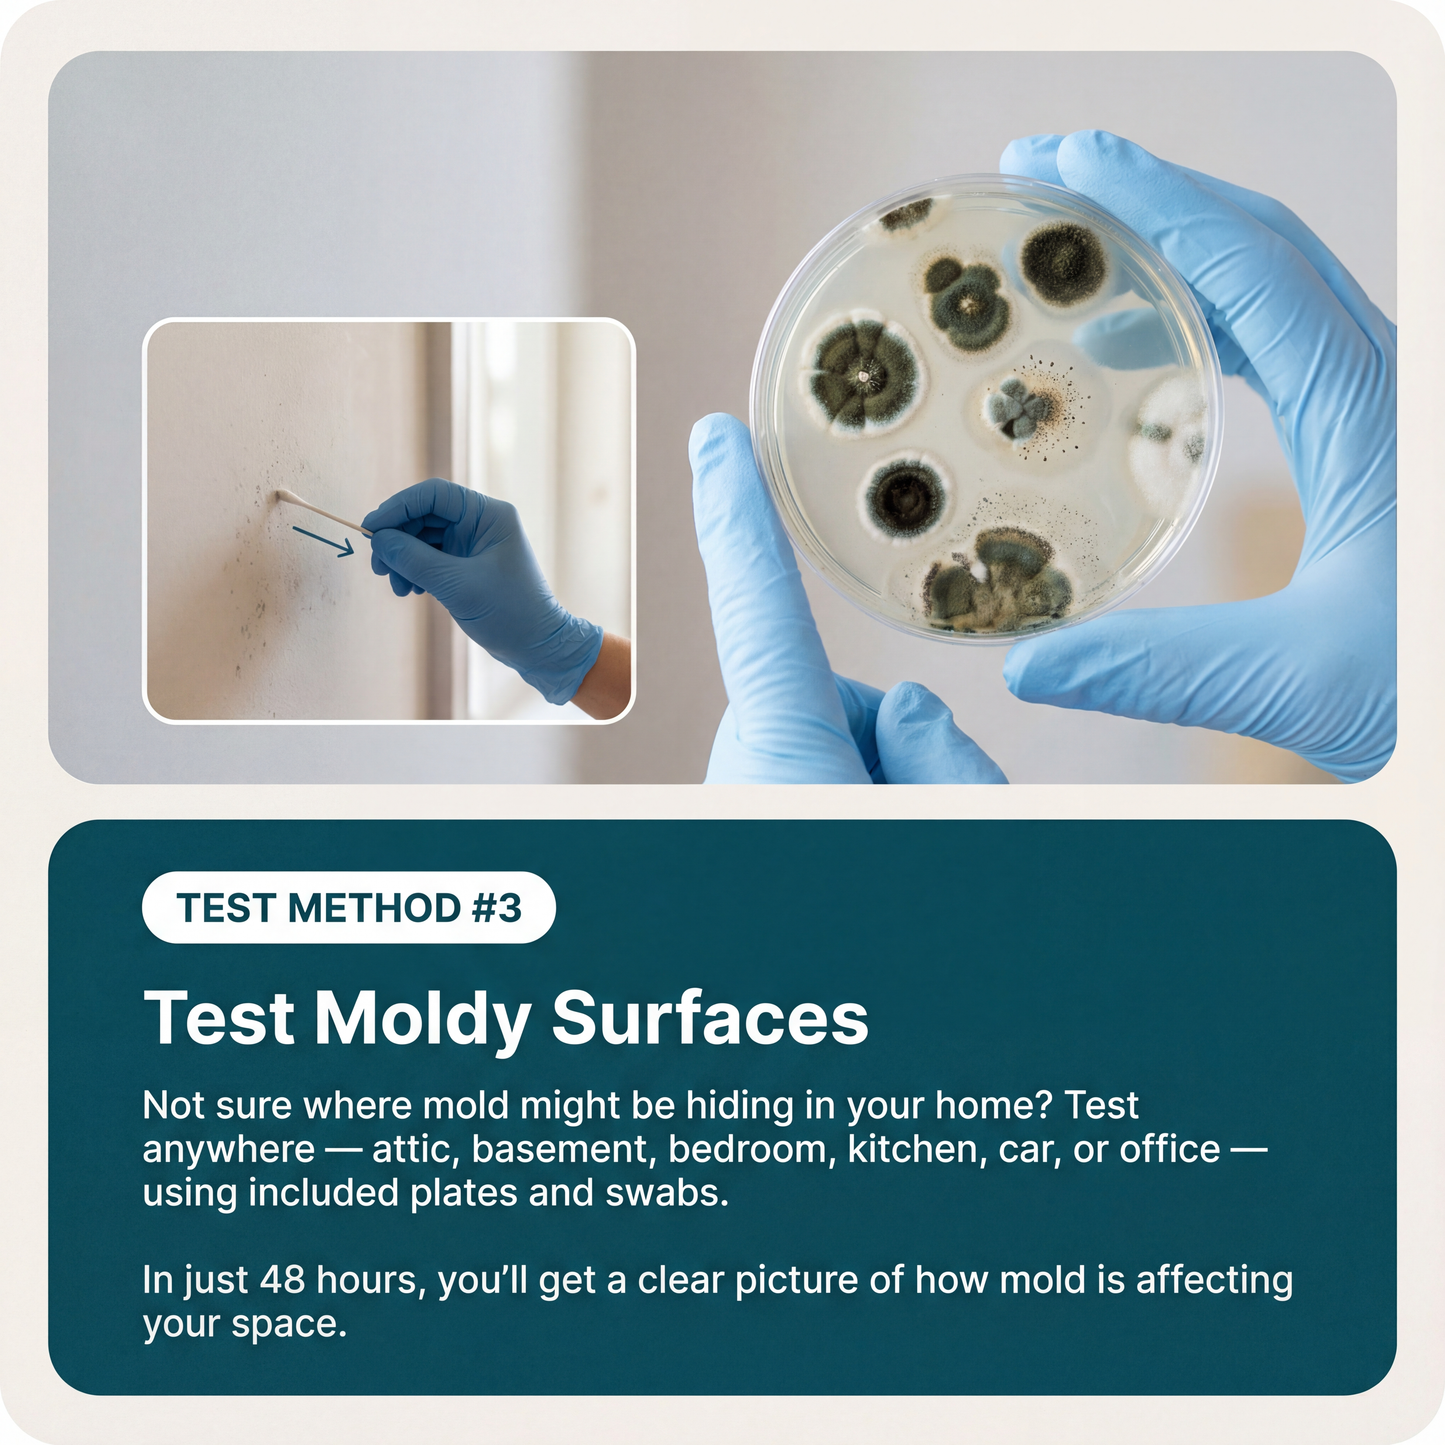
ClearSpace - Home Test Kit
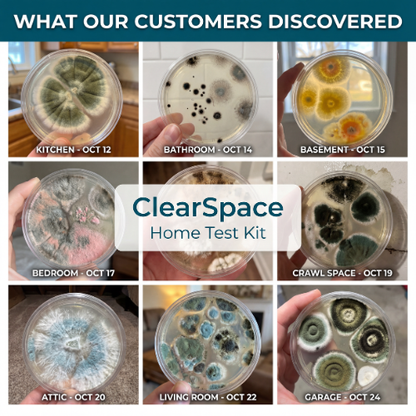
ClearSpace - Home Test Kit
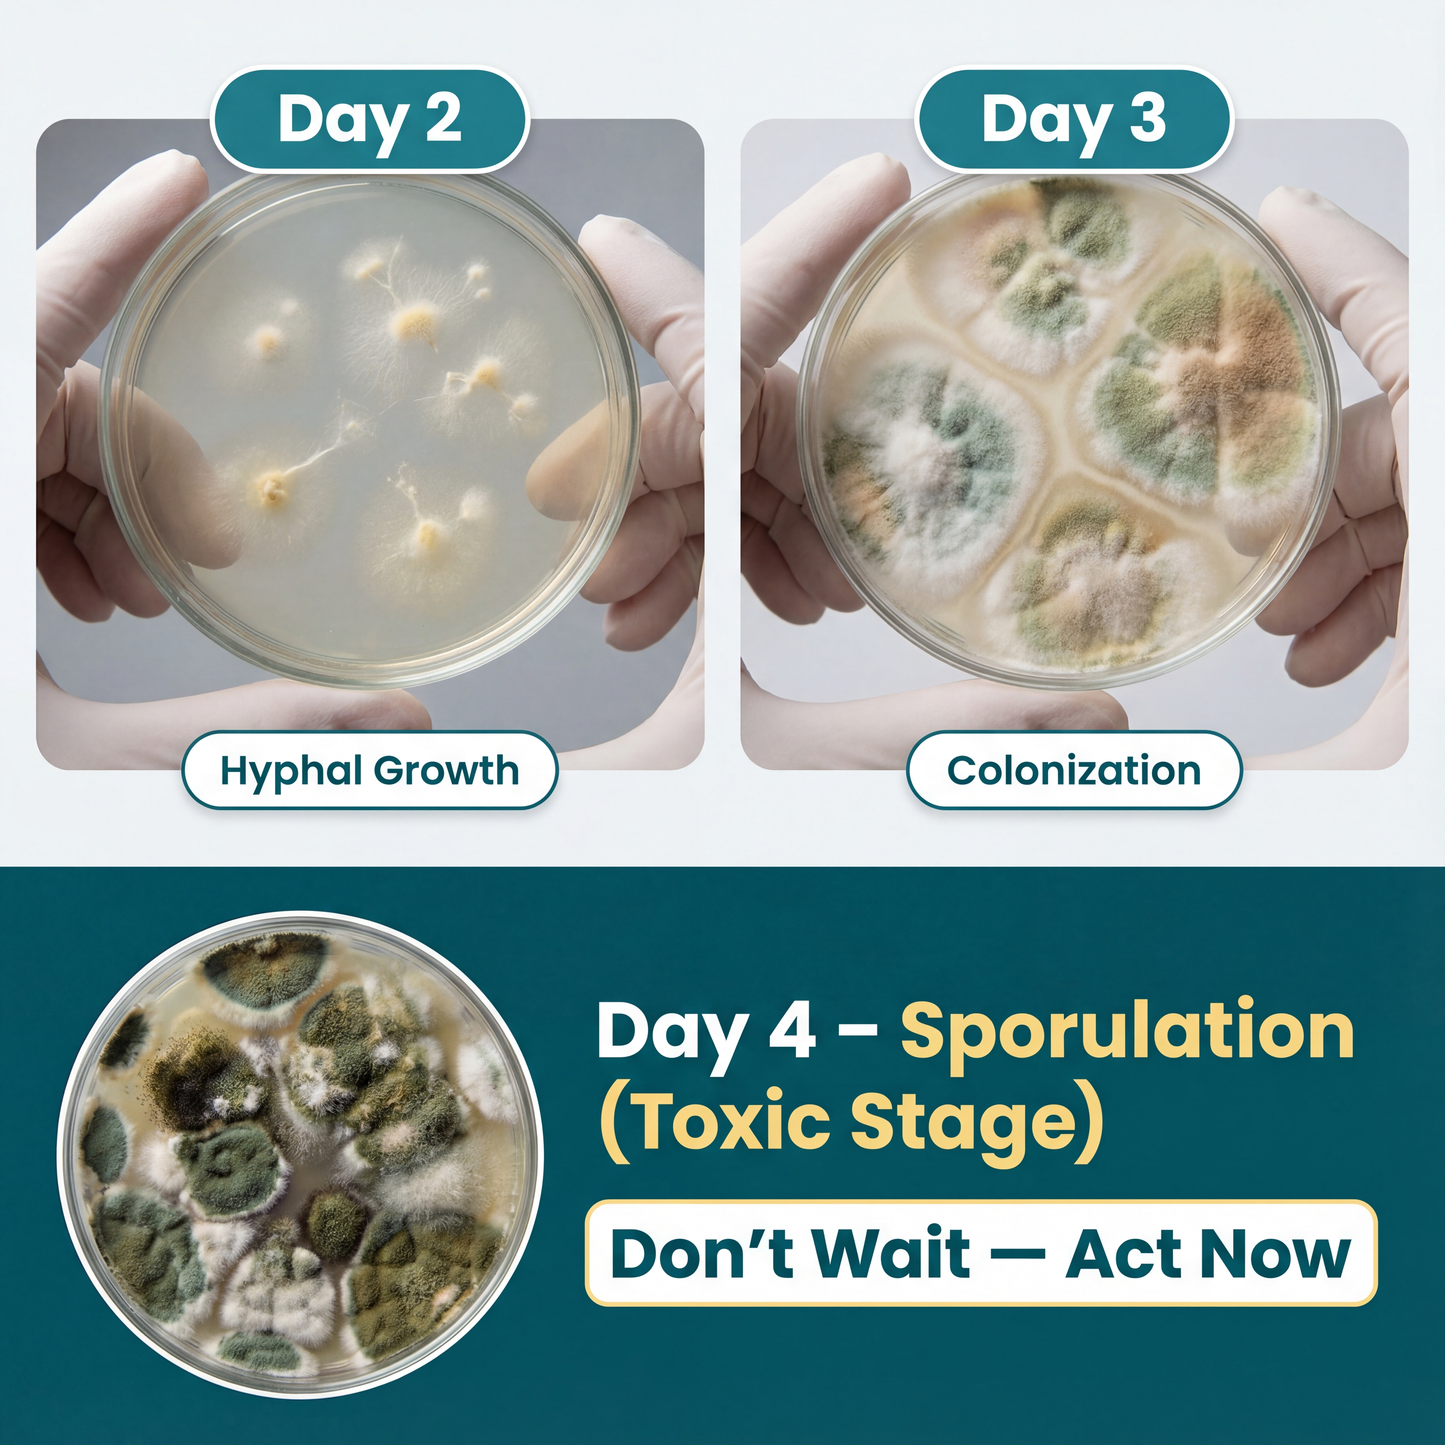
ClearSpace - Home Test Kit

Questions?
We Got Answers
How Is This Different From Cheap Drugstore Tests?
How Is This Different From Cheap Drugstore Tests?
Most store-bought tests use basic indicator strips that only show "mold present" or "no mold" — which is useless since mold is everywhere. Our kit uses the same culture-based detection method professionals use. You'll see actual growth levels across different rooms, so you can pinpoint which areas have dangerous concentrations versus normal background levels.
What If My Results Come Back Positive?
What If My Results Come Back Positive?
The guide included with your kit walks you through exactly what to do based on what you see. Light growth in one area? Usually a simple fix. Heavy growth across multiple rooms? Time to call in a professional. Either way, you'll have clear photographic proof to show inspectors, landlords, or family members who don't believe you.
Can I Use This As Proof For My Landlord?
Can I Use This As Proof For My Landlord?
Yes. Photograph your results, document which rooms tested highest, and present it alongside your symptoms. Many of our customers have used their results to break leases, force remediation, or get taken seriously after being dismissed. It's harder to ignore visible mold growth in a petri dish than "I just don't feel well."
How Accurate Is A DIY Test Compared To Professional Inspection?
How Accurate Is A DIY Test Compared To Professional Inspection?
Professional inspectors charge $500-700+ and use the same culture-based method — they just send samples to a lab and give you a formal report. Our kit uses identical science. The difference is speed (48 hours vs. weeks) and cost. For initial screening or confirming suspicions, this gives you the answers you need without the price tag.
Stop Guessing. Start Knowing.
The 48-hour test that reveals what's hiding in your air — so you can finally take action.
Our Results Speak For Themselves
97%
Found mold in rooms they thought were "clean"
94%
Said results gave them peace of mind or proof to take action
91%
Wish they'd tested sooner instead of waiting for symptoms to get worse




































WHY CHOOSE CLEARSPACE?

|
Others | |
|---|---|---|
Pro-Grade Detection Method |
||
Visible Results In 48 Hours |
||
Test 6+ Areas At Once |
||
No Lab Shipping Required |
||
Expensive |
What People Like You Are Saying
Rated 4.8/5 Stars by 25,000 Happy Customers
Happy Guarantee
We love our ClearSpace and are confident you will too! That’s why we're offering a 14-Day, Risk-Free Trial. If you're not in love with your ClearSpace, we'll give you a 100% refund, no questions asked.